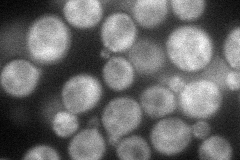
YHR016C
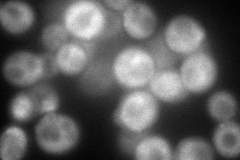
YHR016C
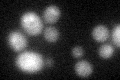
YHR016C

View description
Actin-binding protein involved in bundling of actin filaments and endocytosis of actin cortical patches; activity stimulated by Las17p; contains SH3 domain similar to Rvs167p
Localization:
Intensity:
Fold change:
Significance:
-
C’ GFP library in SD

below threshold15.79 -
N' NOP1pr-GFP in SD
cytosol65.1169 -
N' TEF2pr-mCherry in SD
cytosol,bud neck143.81 -
N' NATIVEpr-GFP in SD

below threshold14.7586 -
N' TEF2pr-VC and Cyto-VN in SD

cytosol,punctate56.2631 -
C’ GFP library in SD+DTT
cytosol18.631.17No -
C’ GFP library in SD+H2O2

cytosol16.251.02No -
C’ GFP library in Starvation Media

cytosol17.291.09No -
C’ GFP library on the background of Pup2-DaMP

below threshold -
C’ GFP library on the background of CCT mutant

below threshold16.50381.04474No
